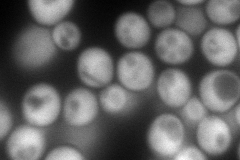
YER090W
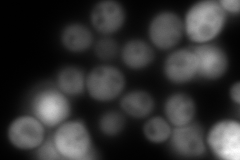
YER090W
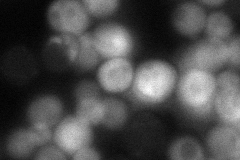
YER090W
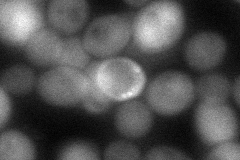
YER090W

View description
Anthranilate synthase, catalyzes the initial step of tryptophan biosynthesis, forms multifunctional hetero-oligomeric anthranilate synthase:indole-3-glycerol phosphate synthase enzyme complex with Trp3p
Localization:
Intensity:
Fold change:
Significance:
-
C’ GFP library in SD

cytosol81.31 -
N' NOP1pr-GFP in SD
cytosol260.695 -
N' TEF2pr-mCherry in SD
cytosol0 -
N' NATIVEpr-GFP in SD
cytosol69.7604 -
N' TEF2pr-VC and Cyto-VN in SD
cytosol72.8638 -
C’ GFP library in SD+DTT

cytosol73.090.89No -
C’ GFP library in SD+H2O2

cytosol79.860.98No -
C’ GFP library in Starvation Media

cytosol53.170.65No -
C’ GFP library on the background of Pup2-DaMP

cytosol -
C’ GFP library on the background of CCT mutant

cytosol96.68841.18895No
